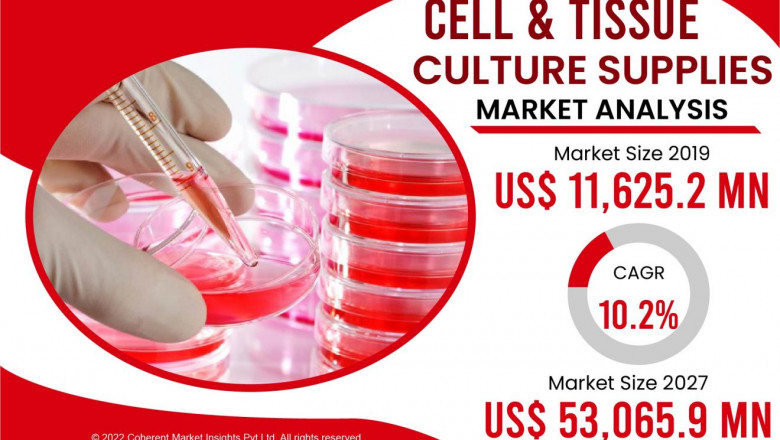

views
January 28th, 2022 Coherent Market Insights Releases
A cell culture is generally retaining the tissues derived out of an origin in an abiotic surrounding active. Several apparatuses which are utilized for unit and serviette extirpating are coat, vessel, container, pipette apparatus, hatchery, freezing tools, ecofriendly container, and many more.
??????? ???? ?????!
??? ??? ?? ????? ???? ??% ???
https://www.coherentmarketinsights.com/insight/buy-now/3770
Statistics:
The overall germ and micro propagation provides merchandise is evaluated to count for US$ 53,065.9 Mn in terms of cost by the completion of 2027
Global Cell and Tissue Culture Supplies Market: Drivers
Expanding Research & Development in the sector of organ and explant technology is anticipated to fuel development of the overall organ and micro propagation offers merchandise in the foresee duration. For example, in March 2020, analysts from Seoul National University, Korea, published a system to design biotechnical-response-persuaded lymph vessel constrict test tube within a PDMS micro fabricated 3D embolic micro propagation policy with a united lofty activated constrict technique.
Furthermore, expanding frequency of persistent illness is also anticipated to assist in development of the merchandise. For example, as per the survey, “Global and regional mellitus frequency evaluates for 2019 and estimates for 2030 and 2045: Outcomes from the International Diabetes Federation Diabetes Atlas, 9th edition”, displayed in the journal Diabetes Research and Clinical Practice, in September 2019, 463 million individuals are anticipated to endure from mellitus in 2019 globally and the count is anticipated to touch 578 million by 2030 and 700 million by 2045.
Global Cell and Tissue Culture Supplies Market: Restraints
Oddest patent and authorization methods are anticipated to hamper development of the merchandise. Strict patent and authorization methods included with regulating organ and micro propagation permits only particular organizations to work in the merchandise. Many connotations such as the American Association of Blood Banks (AABB), the Foundation for the authorization of Cellular Therapy (FACT), the Human Tissue Authority (HTA), and the Joint Authorization Committee – ISCT (Europe) & EBMT (JACIE) are included in patent and authorization method.
Furthermore, difficulty in organ culture methods is also anticipated to specify development of the merchandise. In micro propagation, there are some measures that need a particular surrounding in means to be progressive. Any substitution in the surrounding would cause the alterations in the features of the explant culture, which successively would rise the threat of examining various characters in the commodity made by a system.
The customer’s commodity section in the overall organ and micro propagation provides merchandise was estimated at US$ 11,625.2 Mn in 2019 and is foresee to touch a price of US$ 25,278.6 Mn by 2027 at a CAGR of 10.2% betwixt 2017 and 2027
Market Trends/Key Takeaways
Indenture producing or corrugate analysis is obtaining populace in the sector of organ and micro propagation. Several dominant medicinal organizations, which lack in strong and capable experts, are obtaining agreements with other organizations for analysis in organ and micro propagation. This is anticipated to fuel the merchandise development.
Merchandise move for serum-free agency and fauna-originated compound-free agency has been examined. Several industrialists available in the merchandise have initiated providing serum-free agency because of benefits such as particularity in terms of nutrition and reduced threat of inflammation. Hence, serum-free agency is expensive than serum agency, advantages of the prior reimburse for the cost in the persistent duration. Difficulties of serum agency involve, no particular combination, difference in the outcomes got, threat of inflammation, and less certainty, amidst many more.
Global Cell and Tissue Culture Supplies Market: Competitive Landscape
Main drivers set up in the overall organ and micro propagation offers merchandise involve WHEATON Industries, Merck KGaA, Becton, GE Healthcare, Affymetrix, Dickinson and Company, Corning, Inc., Eppendorf AG, Thermo Fisher Scientific, Inc., Inc., VWR International, Lonza Group, LLC, and Inc.
Global Cell and Tissue Culture Supplies Market: Key Developments
Main companies in the merchandise are aimed on commodity start up to increase their commodity assortment. For example, in February 2020, Eppendorf established SciVario, its new fermenter regulation method for tiny- and bench-range implementations.
In October 2019, Thermo Fisher Scientific established Gibco BenchStable agency in its Gibco commodity line. The new explant culture agency stays constant at room temperature.
Get Sample Report with Latest Covid19 Impact Analysis @ https://www.coherentmarketinsights.com/insight/request-sample/3770
Table of Content
Chapter 1 Industry Overview
1.1 Definition
1.2 Assumptions
1.3 Research Scope
1.4 Market Analysis by Regions
1.5 Global Cell and Tissue Culture Supplies Market Size Analysis from 2022 to 2028
11.6 COVID-19 Outbreak: Cell and Tissue Culture Supplies Industry Impact
Chapter 2 Global Cell and Tissue Culture Supplies Competition by Types, Applications, and Top Regions and Countries
2.1 Global Cell and Tissue Culture Supplies (Volume and Value) by Type
2.3 Global Cell and Tissue Culture Supplies (Volume and Value) by Regions
Chapter 3 Production Market Analysis
3.1 Global Production Market Analysis
3.2 Regional Production Market Analysis
Chapter 4 Global Cell and Tissue Culture Supplies Sales, Consumption, Export, Import by Regions (2017-2022)
Chapter 5 North America Cell and Tissue Culture Supplies Market Analysis
Chapter 6 East Asia Cell and Tissue Culture Supplies Market Analysis
Chapter 7 Europe Cell and Tissue Culture Supplies Market Analysis
Chapter 8 South Asia Cell and Tissue Culture Supplies Market Analysis
Chapter 9 Southeast Asia Cell and Tissue Culture Supplies Market Analysis
Chapter 10 Middle East Cell and Tissue Culture Supplies Market Analysis
Chapter 11 Africa Cell and Tissue Culture Supplies Market Analysis
Chapter 12 Oceania Cell and Tissue Culture Supplies Market Analysis
Chapter 13 South America Cell and Tissue Culture Supplies Market Analysis
Chapter 14 Company Profiles and Key Figures in Cell and Tissue Culture Supplies Business
Chapter 15 Global Cell and Tissue Culture Supplies Market Forecast (2022-2028)
Chapter 16 Conclusions
Research Methodology
Continued….
About Us:
Coherent Market Insights is a global market intelligence and consulting organization that provides syndicated research reports, customized research reports, and consulting services. We are known for our actionable insights and authentic reports in various domains including aerospace and defense, agriculture, food and beverages, automotive, chemicals and materials, and virtually all domains and an exhaustive list of sub-domains under the sun. We create value for clients through our highly reliable and accurate reports. We are also committed in playing a leading role in offering insights in various sectors post-COVID-19 and continue to deliver measurable, sustainable results for our clients.
Contact:
Coherent Market Insights
1001 4th Ave, #3200 Seattle, WA 98154, U.S.
Email: sales@coherentmarketinsights.com
United States of America: +1-206-701-6702
United Kingdom: +44-020-8133-4027
Japan: +050-5539-1737
India: +91-848-285-0837